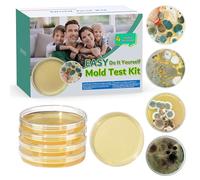

Mold Test Kit for Home Detection: 4 Simple DIY Science Kits for Fastly Testing Home Surfaces & Air Quality Detector & HVAC Monitor Includes Detailed Identification Guide
Mold Test Kit for Home Detection: 4 Simple DIY Science Kits for Fastly Testing Home Surfaces & Air Quality Detector & HVAC Monitor Includes Detailed Identification Guide

Cheapest Total Price
In stock
Direct debit
Direct debit
Visa
Visa
Mastercard
Mastercard
£25.65
Free Delivery
Mold Test Kit for Home Detection: 4 Simple DIY Science Kits for Fastly Testing Home Surfaces & Air Quality Detector & HVAC Monitor Includes Detailed Identification Guide

Usually dispatched within 2 to 3 days
Direct debit
Direct debit
Visa
Visa
Mastercard
Mastercard
£32.09
Free Delivery
🤖 Ask ChatGPT
💡 Is it worth the price?
🔁 Better alternatives?
⭐ What do users say?
Mold Test Kit for Home Detection: 4 Simple DIY Science Kits for Fastly Testing Home Surfaces & Air Quality Detector & HVAC Monitor Includes Detailed Identification Guide - Details
▶ Finding you the best price!
We have found 2 prices for Mold Test Kit for Home Detection: 4 Simple DIY Science Kits for Fastly Testing Home Surfaces & Air Quality Detector & HVAC Monitor Includes Detailed Identification Guide. Our price list is completely transparent with the cheapest listed first. Additional delivery costs may apply.
Mold Test Kit for Home Detection: 4 Simple DIY Science Kits for Fastly Testing Home Surfaces & Air Quality Detector & HVAC Monitor Includes Detailed Identification Guide - Price Information
- Cheapest price: £25.65
- The cheapest price is offered by Amazon-marketplace.co.uk . You can order the product there.
- The price range for the product Mold Test Kit for Home Detection: 4 Simple DIY Science Kits for Fastly Testing Home Surfaces & Air Quality Detector & HVAC Monitor Includes Detailed Identification Guide is €£25.65to €£32.09 with a total of 2 offers.
- Payment methods: The online shop Amazon-marketplace.co.uk supports: Direct debit, Visa, Mastercard
- Delivery: The shortest delivery time is In stock working days offered by Amazon-marketplace.co.uk .
Similar products

£16.85
Amazon-marketplace.co.uk
Delivery from £9.33
Mold Test Kit with 4 Individual Tests - DIY Mold Test Kit for Home - Includes Detailed Mold Identification Guide - Fast Mold Detector and
£31.03
Amazon-marketplace.co.uk
Free Delivery

For Mold Test Kit For Home, 10 Simple -Mold Detection Tests, Optional Lab Analysis, Test HVAC System, Room Air, Home Surfaces For Molds
£17.39
Amazon-marketplace.co.uk
Free Delivery

Mold Test Kit with 4 Individual Tests - DIY Mold Test Kit for Home - Includes Detailed Mold Identification Guide - Fast Mold Detector and
£27.83
Amazon-marketplace.co.uk
Free Delivery

Mold Test Kit with 4 Individual Tests - DIY Mold Test Kit for Home - Includes Detailed Mold Identification Guide - Fast Mold Detector and
£23.89
Amazon-marketplace.co.uk
Free Delivery
Don't forget your voucher code:
Report Illegal Concerns
You are about to report a violation based on the EU Digital Services Act (DSA).